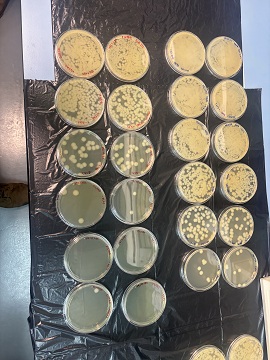

- Home
- UNITS
- Valencia
- 1st NBC Regiment
- News about the Unit
- Listado de noticias de unidad
MENÚ UNIDAD
ARMY UNITS
- Araba Álava |
- Albacete |
- Alicante |
- Almería |
- Asturias |
- Ávila |
- Badajoz |
- Barcelona |
- Burgos |
- Cáceres |
- Cádiz |
- Cantabria |
- Castellón |
- Ceuta |
- Ciudad Real |
- Córdoba |
- A Coruña |
- Cuenca |
- Girona |
- Granada |
- Guadalajara |
- Gipuzkoa |
- Huelva |
- Huesca |
- Islas Baleares |
- Jaén |
- León |
- Lleida |
- Lugo |
- Madrid |
- Málaga |
- Melilla |
- Murcia |
- Navarra |
- Ourense |
- Palencia |
- Las Palmas |
- Pontevedra |
- La Rioja |
- Salamanca |
- Segovia |
- Sevilla |
- Soria |
- Tarragona |
- Santa Cruz de Tenerife |
- Teruel |
- Toledo |
- Valencia |
- Valladolid |
- Bizkaia |
- Zamora |
- Zaragoza

News about the Unit
Listado de noticias de unidad
- pagination
-
Tuesday, December 30, 2025
El Regimiento de Defensa NBQ "Valencia" nº1 participa en EXPOJOVE 2026
El Regimiento de Defensa NBQ “Valencia” nº1 del Ejército de Tierra ha participado activamente en la ExpoJove 2026, que se celebra en la Feria de Muestras de Paterna (Valencia)
-
Wednesday, November 26, 2025
El Ejército de Tierra potencia sus capacidades de descontaminación NBQ
El pasado día 26 de noviembre, la Dirección de Adquisiciones del Mando de Apoyo Logístico (MALE) del Ejército de Tierra (ET), recepcionó en el Acuartelamiento “Daoíz y Velarde” de Paterna (Valencia) tres nuevos SDGM.
-
Thursday, November 20, 2025
EL RNBQ1 colabora con la Universidad Católica de Valencia
Enmarcado en el Convenio entre el Ministerio de Defensa y la Universidad Católica de Valencia San Vicente Mártir, para la realización de actividades docentes, de investigación, difusión y debate y de cualquier otro ámbito de interés mutuo, durante los días 20 y 21 de noviembre de 2025, personal del Regimiento de Defensa NBQ “Valencia” nº 1 (RNBQ1) junto con la Universidad Católica de Valencia (UCV) San Vicente Mártir, llevaron a cabo las Jornadas de Emergencias Nucleares, Biológicas y Químicas.
-
Monday, November 17, 2025
Ejercicio Spertzel 25, paso final en la preparación del Laboratorio Biológico Desplegable del Ejército de Tierra.
Del 17 al 28 de noviembre de 2025, el Laboratorio Biológico Desplegable (LBD), encuadrado en la Unidad Técnica Específica II/1 (UTE II/1) del RNBQ1, ha ejecutado el Ejercicio SPERTZEL 25, bajo la dirección y supervisión del Área de Defensa Biológica del Departamento de Sistemas de Defensa NBQ y Materiales Energéticos del INTA Campus “La Marañosa”, en sus instalaciones de San Martín de la Vega
-
Monday, November 17, 2025
El Vehículo de Reconocimiento NBQ ¨PITON” del RNBQ1 participa en el Ejercicio Beta GIETMA junto a la Unidad Militar de Emergencias (UME).
Durante la semana del 17 al 21 de noviembre de 2025 un equipo de reconocimiento NBQ sobre vehículo “PITON” del Regimiento de Defensa NBQ “Valencia” nº 1 (RNBQ1), participó en el Ejercicio liderado por el Grupo de Intervención en Emergencias Tecnológicas y Medioambientales
-
Wednesday, November 12, 2025
El Batallón de Defensa NBQ I/1 realiza una marcha a pie en la ruta fluvial del río Turia
El pasado 12 de noviembre de 2025 el Batallón de Defensa NBQ I/1, localizado en el Acuartelamiento Daoíz y Velarde de Paterna, realizó una marcha a pie siguiendo el río Turia.
-
Wednesday, November 12, 2025
4ª Jornada ACINTER en Paterna
El Regimiento de Defensa NBQ “Valencia” Nº1 (RNBQ1) y la Escuela Militar de Defensa NBQ (EMDNBQ) han dirigido el 12 de noviembre, en el Acuartelamiento Daoíz y Velarde de Paterna (Valencia), la 4ª Jornada de Apoyo Científico y Tecnológico para la Defensa NBQ del Ejército de Tierra (ACINTER).
-
Friday, November 7, 2025
Acto homenaje a los que dieron su vida por España
El pasado 7 de noviembre de 2025 tuvo lugar un Acto de Homenaje a los que dieron su vida por España en el Patio de Armas “Isabel I” del Acuartelamiento Daoíz y Velarde de Paterna.
-
Friday, October 31, 2025
Finaliza el ejercicio Grifo 25, referente en la Defensa NBQ de la Fuerza Terrestre
Del 25 al 31 de octubre de 2025 se desarrolló, en diversas localidades de las provincias de Valencia y Castellón, la segunda fase del ejercicio “Grifo 25”, enfocado a mejorar la preparación de unidades NBQ de distintos ejércitos y nacionalidades, frente a situaciones de amenaza nuclear, biológica y química (NBQ).
-
Monday, October 27, 2025
Visita al ejercicio GRIFO 25 del Jefe del Regimiento Hermano NBQ Italiano
El día 27 de octubre de 2025, enmarcado en el programa de cooperación bilateral entre España e Italia (2025), una delegación del 7º Regimiento CBRN Cremona (Italia), liderada por su Jefe, Coronel Dario De Masi, visitó el ejercicio Grifo 25 en los campos de maniobras de Bétera y Marines (Valencia).
-
Sunday, October 26, 2025
Ejercicio Grifo 25: mejorando la interoperabilidad de las unidades NBQ
Durante los días 25 y 26 de octubre de 2025 las unidades NBQ de las FAS españolas, italianas y francesas, junto a la Guardia Civil, se adiestraron conjuntamente, en el marco del ejercicio Grifo 25, en diferentes localizaciones de las provincias de Valencia y Castellón.
-
Monday, October 20, 2025
Mejorando juntos la Defensa NBQ
Del 20 al 27 de octubre de 2025 se ha desarrollado la primera fase del ejercicio “Grifo 25”, enfocado a mejorar la preparación de las unidades NBQ de la Fuerza Terrestre (FUTER) del Ejército de Tierra (ET) frente a la amenaza nuclear, biológica y química (NBQ).
-
Monday, October 13, 2025
Instrucción con el EPI previa al ejercicio Grifo 25
El pasado lunes 13 de octubre, el personal del Regimiento de Defensa NBQ “Valencia” nº1 (RNBQ1) realizó un recorrido uniformado con el equipo de protección individual (EPI) en el interior del Acuartelamiento Daoíz y Velarde (Paterna).
-
Wednesday, October 8, 2025
Visita al 2e Regiment de Dragons del Ejercito de Tierra Francés
Enmarcado en el programa de cooperación bilateral entre España y Francia, el Coronel Jefe y el Suboficial Mayor del Regimiento de Defensa NBQ “Valencia” N.º 1 (RNBQ1) visitaron, el 8 de octubre de 2025, el “2e Régiment de Dragons” ubicado en las cercanías del pueblo donde está enterrado el rey inglés Ricardo Corazón de León, Fontevraud- l’Abbaye, a 15 km de Saumur.
-
Tuesday, October 7, 2025
Vista delegación japonesa al vehículo NBQ PITON
El pasado día 7 de octubre de 2025, el Regimiento de Defensa NBQ Valencia nº1 (RNBQ1) recibió, en sus instalaciones del Acuartelamiento Daoíz y Velarde de Paterna, la visita de personal del Grupo Escribano (EM&E) acompañado de una delegación japonesa. La visita se centró en comprobar de primera mano el funcionamiento del kit de toma de muestras integrado en el brazo robótico del vehículo de Reconocimiento NBQ PITON.
-
Thursday, September 25, 2025
Visita al Regimiento Hermano NBQ Italiano
Enmarcado en el programa de cooperación bilateral entre España e Italia (2025), el coronel jefe y el suboficial mayor del Regimiento de Defensa Nuclear, Biológico y Químico “Valencia” N.º 1 (RNBQ1) visitaron, el 25 de septiembre de 2025, el 7ª Reggimento Difesa CBRN “Cremona” italiano
-
Sunday, September 14, 2025
Celebración del Centenario de la Coronación del Santísimo Cristo de la Fe en Paterna
El 14 de septiembre de 1925, el Cardenal Benlloch ofició la ceremonia de coronación del Santísimo Cristo de la Fe en las instalaciones del que es actualmente el Acuartelamiento Daoíz y Velarde de Paterna, más concretamente frente a la estación telegráfica construida en 1913.
-
Saturday, September 6, 2025
TOXIC AGGRESSOR 25, Unidades NBQ Españolas se preparan con agentes químicos reales en Serbia
Del 6 al 13 de septiembre de 2025, personal de las unidades NBQ de la UME, de las Brigadas I, VI, XI, XVI y del Regimiento de Defensa NBQ “Valencia” nº 1 (RNBQ1), liderados por este último, han participado en la fase I básica del Ejercicio Toxic Aggressor 25 (TOAG25). Esta fase del ejercicio, del tipo Live Agent Training (LAT), se ha desarrollado en el CBRN Centre, situado en Krusevac (Serbia).
-
Monday, September 1, 2025
Procesión en honor al Santisimo Cristo de la Fe en Paterna
El Regimiento de Defensa NBQ “Valencia” nº 1 (RNBQ1), como viene siendo tradicional, ha tenido el honor de participar una vez más en la solemne procesión en honor del Santísimo Cristo de la Fe de Paterna, la cual se llevó a cabo el 1 de septiembre por las calles de dicha ciudad.
-
Thursday, July 17, 2025
Jornadas Formativas del Detector Químico Falcon 4G
Entre los días 15 y 16 de julio se celebraron las Jornadas Formativas orientadas al empleo del sistema Falcon 4G el Acuartelamiento Daoíz y Velarde de Paterna.
-
Monday, July 7, 2025
Ejercicio “Hades 25”, preparándose para operar en ambiente radiactivo.
El Regimiento de Defensa NBQ “Valencia” Nº 1 (RNBQ1) ha realizado una nueva edición del ejercicio “HADES” en las instalaciones del Centro de Investigaciones Energéticas, Medioambientales y Tecnológicas (CIEMAT), en Madrid, entre los días 1 y 4 de julio de 2025.
-
Wednesday, July 2, 2025
XII Reunión del Panel Fusión de Conocimientos NBQ
El pasado 2 de julio se celebró la XII Reunión del Panel Fusión de Conocimientos NBQ en el Acuartelamiento Daoíz y Velarde de Paterna.
-
Wednesday, June 25, 2025
Acto de homenaje a los que dieron su vida por España
El 25 de junio de 2025, el Regimiento de Defensa NBQ “Valencia” nº 1 realizó un Acto de Homenaje a los que dieron su vida por España en el Patio Isabel I del Acuartelamiento Daoíz y Velarde de Paterna.
-
Friday, June 20, 2025
“Ave Fénix 25”. Mejorando la capacidad de las Células de Defensa NBQ españolas.
El Regimiento de Defensa NBQ “Valencia” Nº1 (RNBQ1) ha dirigido y ejecutado, del 16 al 20 de junio, el ejercicio Ave Fénix 25 en el Acto. Daoíz y Velarde de Paterna (Valencia).
-
Monday, June 9, 2025
Mejorando la formación en el Área Química del personal del Regimiento
Entre los días 09 y 13 de junio, en el marco del plan de actividades bilaterales con Serbia, se llevó a cabo el curso “Detection of toxic chemicals and toxic industrial chemicals (TIC)” en la localidad de Krusevac.
-
Monday, May 12, 2025
El Regimiento de Defensa Nuclear, Biológico y Químico “Valencia” nº 1 participa en FEINDEF 25
El Regimiento de Defensa NBQ “Valencia” nº 1 (RNBQ1), unidad del ET, ha participado, del 12 al 14 de mayo de 2025, en la Feria Internacional de Defensa y Seguridad de España (FEINDEF), llevada a cabo en las instalaciones de la Institución Ferial de Madrid (IFEMA).
-
Tuesday, May 6, 2025
Visita del Deputy Commander del HQ NRDC-ESP al Regimiento de Defensa NBQ “Valencia” nº1
El pasado miércoles 30 de abril, el Deputy Commander (DCOM) del HQ NRDC-ESP, el General de División del Ejército portugués Sergio Valente Marques, visitó al Regimiento de Defensa NBQ “Valencia” nº 1 (RNBQ 1) en sus instalaciones del Acuartelamiento Daoíz y Velarde de Paterna (Valencia).
-
Sunday, May 4, 2025
Ejercicio BRAVE BEDUIN 25, esencial para el adiestramiento de los Centros de Control NBQ de la OTAN
Los Centros de Control NBQ (CCNBQ) del Regimiento de Defensa NBQ “Valencia” Nº1 (RNBQ1), de otras unidades NBQ de Fuerza Terrestre (FUTER) y del Mando de Canarias (MCANA), han participado en el Ejercicio “BRAVE BEDUIN 25”, desarrollado del 4 al 8 de mayo de 2025 en la localidad de Skive (Dinamarca).
-
Thursday, April 10, 2025
El General Jefe del Mando de Apoyo a la Maniobra visita el Regimiento de Defensa NBQ “Valencia” nº1
El pasado jueves 10 de abril, el general Marcial González Prada, Jefe del Mando de Apoyo a la Maniobra (GEMAM), efectuó su primera visita al Regimiento de Defensa NBQ “Valencia” nº 1 (RNBQ1) en sus instalaciones del Acuartelamiento “Daoíz y Velarde” de Paterna (Valencia).
-
Friday, April 4, 2025
Celebración del aniversario de la creación del Regimiento de Defensa NBQ “Valencia” nº 1
El pasado viernes 4 de abril, el Regimiento de Defensa NBQ “Valencia” nº 1 realizó su ceremonia militar anual para conmemorar el XX aniversario de su creación, en el Acuartelamiento Daoíz y Velarde en Paterna (Valencia). La ceremonia fue presidida por el general José Manuel Roy Calvo, Jefe del Mando de Transmisiones y Comandante Militar de Valencia y Castellón.